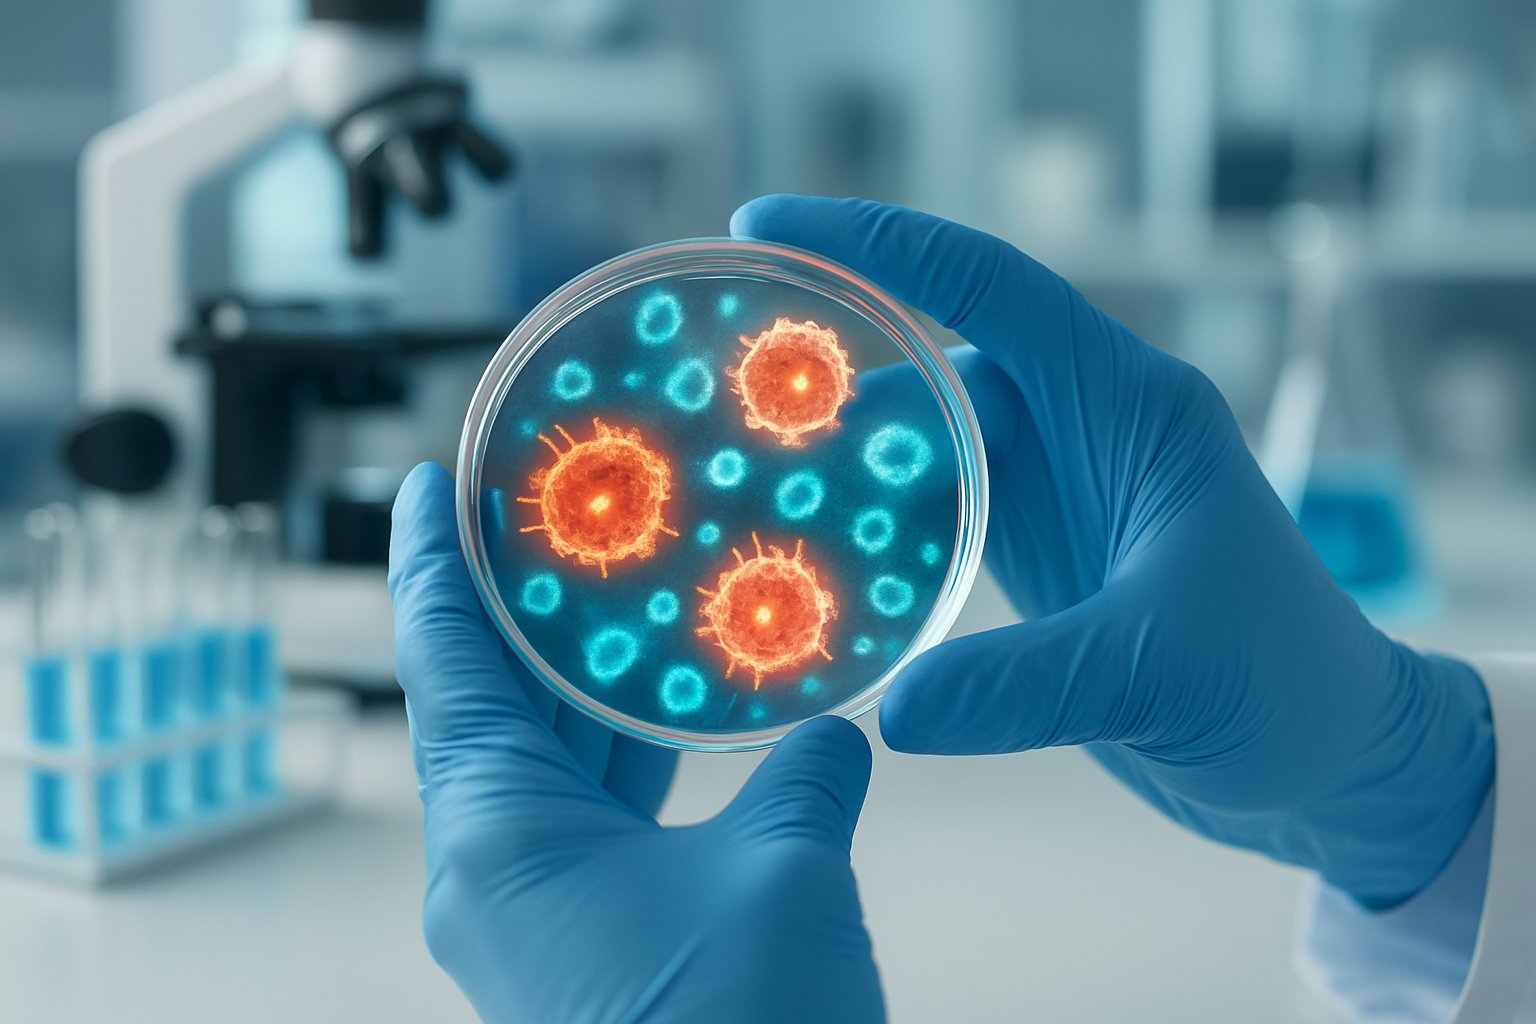

Quercetin combined with dasatinib represents the most promising senolytic combination based on current research. Natural compounds like fisetin and dietary sources provide gentler alternatives but may require higher doses for effectiveness. Most commercially available senolytic supplements contain doses too low to produce meaningful results.
Senescent cells accumulate in the body as people age, contributing to inflammation and age-related diseases. These “zombie cells” have stopped dividing but remain in tissues, releasing harmful signals that damage surrounding healthy cells. Senolytics are compounds designed to target and eliminate these problematic cells.

Quercetin and dasatinib used together have shown the most promise[1] as effective senolytics, targeting senescent cells across multiple tissues. This combination includes a natural flavonoid found in foods like apples and onions paired with a pharmaceutical originally developed for cancer treatment. Animal studies and early human trials have demonstrated improvements in physical function and reduced inflammation.
Other compounds like fisetin, navitoclax, and curcumin also show potential as senolytics. However, supplements are often sold at doses much lower than needed to be effective[2], and more research is needed to establish optimal protocols and long-term safety in humans.
Understanding Senolytics and Cellular Senescence

Cellular senescence occurs when cells stop dividing and become damaged, releasing harmful substances that cause chronic inflammation. Senolytics are drugs designed to remove these problematic cells from the body.
Roles of Senescent and Zombie Cells
Senescent cells are damaged cells that no longer divide or function properly. Scientists often call them “zombie cells” because they stay alive but cause harm to surrounding healthy tissue.
These cells release inflammatory molecules through a process called SASP (senescence-associated secretory phenotype). The SASP creates chronic inflammation that damages nearby cells and organs.
Zombie cells accumulate in tissues over time. They make up only a small percentage of total cells but cause significant problems. Research shows they contribute to many age-related health issues.
The inflammatory substances these cells release include:
- Cytokines that trigger immune responses
- Growth factors that can promote tumor growth
- Matrix proteins that break down healthy tissue
Normal senescent cells serve some useful purposes in young people. They help with wound healing and prevent damaged cells from becoming cancerous. However, the body’s ability to remove them decreases with age.
What Triggers Cellular Senescence
Several factors cause cells to become senescent. DNA damage is one of the most common triggers of cellular aging.
Oxidative stress plays a major role in creating senescent cells. This happens when harmful molecules called free radicals damage cell parts. The body’s natural antioxidant systems become less effective over time.
Other triggers include:
- Chronic infections
- Toxic chemical exposure
- Radiation damage
- Shortened telomeres (protective DNA caps)
- Mechanical stress on tissues
Age is the biggest risk factor. The number of senescent cells increases significantly after age 60. However, some people develop more zombie cells earlier due to genetics or lifestyle factors.
Chronic diseases can also speed up cellular senescence. Diabetes, heart disease, and autoimmune conditions create ongoing stress that damages cells faster than normal.
Risks Associated with Cellular Aging
Senescent cells contribute to many serious health problems. They accelerate the aging process and increase disease risk.
Chronic inflammation from zombie cells affects multiple organ systems. This low-level inflammation damages blood vessels, joints, and brain tissue over time.
Major health risks include:
- Heart disease and stroke
- Type 2 diabetes
- Alzheimer’s disease
- Cancer development
- Kidney and liver problems
- Bone loss and muscle weakness
The accumulation of senescent cells creates a cycle of damage. As more cells become senescent, inflammation increases throughout the body. This inflammation then causes more healthy cells to become damaged.
Research shows that removing senescent cells can improve health in laboratory animals. This discovery led scientists to develop senolytics as potential treatments for age-related diseases.
Studies suggest that targeting zombie cells could help people live healthier lives as they age. However, more research is needed to understand the long-term effects of senolytic treatments in humans.
How Senolytics Work
Senolytics function by targeting aged cells that have stopped dividing but remain alive in tissues, causing damage through inflammatory signals. These compounds overcome cellular resistance mechanisms and restore the body’s natural cleanup processes.
Selective Targeting of Senescent Cells
Senescent cells develop unique survival mechanisms that help them resist normal cell death. They increase anti-apoptotic proteins and alter their cellular pathways to stay alive longer than healthy cells would.
Senescent Cell Anti-Apoptotic Pathways (SCAPs) include:
- BCL-2 family proteins that block cell death
- p53 pathway alterations that prevent apoptosis
- PI3K/AKT signaling that promotes survival
- Heat shock proteins that protect against stress
Senolytics disable these pro-survival networks[3] by targeting specific proteins and pathways. Different senolytic compounds work on different survival mechanisms.
Fisetin targets BCL-2 proteins directly. Quercetin works through multiple pathways including PI3K/AKT signaling. This is why combining different senolytics may be more effective than using single compounds.
The selectivity comes from senescent cells’ dependence on these survival pathways. Normal healthy cells don’t rely as heavily on the same mechanisms for survival.
Mechanisms of Apoptosis and Cellular Clean-Up
Once senolytics disable survival pathways, senescent cells undergo apoptosis – the body’s normal process for removing unwanted cells. This programmed cell death happens in an organized way that doesn’t harm nearby tissues.
During apoptosis, cells shrink and break into small pieces called apoptotic bodies. Immune cells called macrophages then engulf and digest these remains through a process called phagocytosis.
The apoptotic process includes:
- Cell membrane changes that signal for removal
- DNA fragmentation and protein breakdown
- Formation of membrane-bound apoptotic bodies
- Recognition and uptake by immune cells
This cellular clean-up prevents the release of harmful cellular contents. Unlike other forms of cell death, apoptosis doesn’t trigger inflammation or damage surrounding tissues.
The immune system’s ability to clear senescent cells naturally declines with age. Senolytics help restore this balance by making resistant cells vulnerable to removal again.
Impact on Inflammation and Tissue Repair
Senescent cells produce hundreds of inflammatory molecules called the Senescence-Associated Secretory Phenotype (SASP). These include cytokines, chemokines, and enzymes that damage nearby tissues and promote chronic inflammation.
SASP factors create a harmful cycle where inflammation causes more cells to become senescent. This leads to persistent oxidative stress and tissue dysfunction throughout the body.
By eliminating senescent cells, senolytics stop the production of these inflammatory signals at their source. This allows tissues to shift from a state of chronic inflammation to one that supports healing and regeneration.
Key benefits include:
- Reduced inflammatory cytokine levels
- Decreased oxidative stress markers
- Improved tissue repair capacity
- Enhanced stem cell function
The removal of senescent cells also helps restore normal immune signaling. This allows the body’s natural repair mechanisms to function more effectively and supports healthy tissue repair processes.
Criteria for an Effective Senolytic

The best senolytic compounds must meet three essential standards: they need strong targeting power, good absorption in the body, and minimal harmful effects. These factors determine whether a senolytic activator will actually work in real-world treatment.
Potency and Selectivity
Effective senolytics must kill senescent cells while leaving healthy cells untouched. This selective targeting prevents damage to normal tissue.
The compound needs high potency at low doses. Strong senolytic properties mean less medication is required for results.
Key selectivity markers include:
- Targeting specific senescent cell proteins
- Avoiding healthy cell death pathways
- Working across different tissue types
Quercetin and dasatinib show strong synergistic targeting[1] across multiple tissues. Their combination approach hits senescent cells more effectively than single compounds.
Fisetin demonstrates excellent selectivity. It clears senescent cells without harming neighboring healthy tissue.
The ideal senolytic activator triggers apoptosis only in damaged cells. This precision prevents unwanted side effects from widespread cell death.
Bioavailability and Absorption
A compound’s bioavailability determines how much reaches target tissues. Poor absorption makes even potent senolytics ineffective.
Natural compounds like quercetin have low bioavailability when taken orally. Most gets broken down before reaching senescent cells.
Factors affecting absorption:
- Molecular size and structure
- Fat or water solubility
- First-pass liver metabolism
- Food interactions
Liposomal formulations improve bioavailability. They protect compounds during digestion and enhance cellular uptake.
Synthetic senolytics like dasatinib often have better absorption than natural alternatives. Their pharmaceutical design optimizes tissue penetration.
Timing and dosing affect bioavailability. Some compounds work better on empty stomachs or in divided doses.
Safety and Tolerability
Safe senolytics cause minimal adverse effects during treatment. Long-term safety remains crucial for aging interventions.
Commercial senolytic supplements often contain doses too low to be effective[2]. Higher therapeutic doses may increase risk of side effects.
Common safety concerns:
- Blood clotting problems
- Digestive upset
- Drug interactions
- Kidney or liver stress
Natural senolytics generally show better safety profiles. Quercetin and fisetin cause fewer serious side effects than pharmaceutical options.
Dasatinib carries bleeding risks due to platelet reduction. This limits its use in certain populations.
The therapeutic window matters significantly. Effective doses should remain well below toxic levels for safe long-term use.
Leading Senolytic Compounds

Several senolytic compounds have emerged as the most promising options for targeting senescent cells. Fisetin ranks as the most potent senolytic[3] among natural compounds, while pharmaceutical options like dasatinib and navitoclax offer different mechanisms of action.
Fisetin and Liposomal Fisetin
Fisetin stands out as a powerful natural senolytic compound derived from strawberries and other fruits. Research shows that fisetin was the most potent senolytic[3] when scientists tested 10 different flavonoid compounds on senescent cells from humans and mice.
This flavonoid works by disrupting the survival pathways that allow senescent cells to resist normal cell death. Studies indicate fisetin can cross the blood-brain barrier, making it particularly valuable for addressing senescent cells in brain tissue.
Liposomal fisetin represents an advanced delivery method that improves absorption and bioavailability. The liposomal coating protects fisetin from digestive breakdown and helps transport it directly into cells.
Traditional fisetin supplements often have poor absorption rates. Liposomal formulations can increase bioavailability by up to 10 times compared to standard fisetin powder.
Clinical trials are currently underway to test fisetin’s effects on vascular function in older adults. These studies will help determine optimal dosing and long-term safety profiles.
Quercetin
Quercetin is a well-studied flavonoid found in onions, apples, and berries that demonstrates significant senolytic activity. This compound has been extensively tested in combination with other senolytic drugs in clinical settings.
The compound works by inhibiting specific proteins that help senescent cells survive. Quercetin targets the BCL-2 family of proteins, which are essential for senescent cell survival mechanisms.
Clinical applications of quercetin have shown promising results. Studies in humans with metabolic dysfunction found that quercetin reduced markers of cellular senescence in blood, skin, and fat tissue.
Quercetin typically requires higher doses than fisetin to achieve senolytic effects. Most research uses doses between 500-1000mg per day when combined with other compounds.
The compound also provides additional antioxidant and anti-inflammatory benefits beyond its senolytic properties. This makes quercetin a versatile option for overall health support.
Dasatinib
Dasatinib is a prescription cancer drug that has gained attention for its potent senolytic properties. Originally developed to treat certain types of leukemia, researchers discovered its ability to eliminate senescent cells.
This pharmaceutical compound works differently than natural senolytics. Dasatinib inhibits specific kinase enzymes that senescent cells depend on for survival.
Studies involving dasatinib and quercetin revealed significant improvements[1] in aging symptoms like frailty and cognitive decline in animal models. The combination showed better results than either compound alone.
Dosing protocols for dasatinib as a senolytic differ greatly from cancer treatment doses. Senolytic applications use much lower doses given intermittently rather than daily.
The drug requires medical supervision due to potential side effects. These can include low blood cell counts, bleeding risks, and interactions with other medications.
Navitoclax
Navitoclax represents one of the most potent pharmaceutical senolytic compounds currently under investigation. This experimental drug was originally developed as a cancer treatment but shows remarkable senolytic activity.
The compound targets BCL-2 family proteins with high precision. These proteins are crucial for senescent cell survival, making navitoclax extremely effective at inducing senescent cell death.
Preclinical studies demonstrate that navitoclax can eliminate senescent cells from multiple tissue types. Research shows effectiveness in lung, liver, kidney, and fat tissues.
The drug’s potency means it requires very low doses to achieve senolytic effects. This reduces the risk of side effects compared to higher-dose treatments.
Current limitations include the need for careful medical monitoring. Navitoclax can affect platelet function, requiring regular blood tests during treatment periods.
Natural Senolytics and Dietary Approaches

Several plant-based compounds show strong senolytic activity through different mechanisms. These natural senolytic compounds work as antioxidants while targeting senescent cells specifically.
Apigenin, Piperlongumine, and Flavonoids
Apigenin stands out among flavonoids for its dual approach to cellular aging. This compound found in chamomile, parsley, and celery targets the toxic secretions that senescent cells release.
Research shows apigenin inhibits the senescence-associated secretory phenotype (SASP). This means it reduces the inflammatory compounds that senescent cells pump out to damage nearby healthy tissue.
The flavonoid works differently than other natural senolytics. Instead of just killing senescent cells, it stops them from spreading their toxic effects.
Piperlongumine from long pepper plants attacks senescent cells through oxidative stress pathways. It selectively targets damaged cells while leaving healthy ones alone.
Other important flavonoids include:
- Quercetin from onions and berries
- Kaempferol from kale and broccoli
- Luteolin from artichokes and peppers
These natural senolytic compounds[4] work best when combined rather than used alone.
Green Tea, EGCG, and Resveratrol
Green tea extract contains powerful senolytic molecules called catechins. The most active compound is EGCG (epigallocatechin gallate).
EGCG works by triggering apoptosis in senescent cells. Studies show it can remove up to 40% of damaged cells in laboratory tests.
Black tea theaflavins offer even stronger effects than green tea compounds. Research indicates theaflavins[5] block proteins that help senescent cells survive.
Resveratrol from red grapes and berries activates longevity pathways while clearing senescent cells. It mimics some effects of calorie restriction on cellular aging.
The compound works through multiple mechanisms:
- Activates SIRT1 longevity genes
- Reduces inflammatory markers
- Improves mitochondrial function
- Triggers senescent cell death
Drinking 3-4 cups of green tea daily provides moderate senolytic benefits. However, concentrated extracts deliver much higher active compound levels.
Curcumin, Turmeric, and Piperine
Turmeric contains curcumin, which shows moderate senolytic activity combined with strong anti-inflammatory effects. The spice targets multiple aging pathways simultaneously.
Curcumin’s senolytic power comes from its ability to disrupt cellular survival signals in damaged cells. It also reduces the inflammatory cascade that senescent cells create.
Piperine from black pepper dramatically increases curcumin absorption. Without piperine, the body eliminates most curcumin before it can work effectively.
Studies show piperine increases curcumin bioavailability by up to 2000%. This combination makes turmeric supplements much more effective than the spice alone.
The curcumin-piperine combination offers these benefits:
- Reduces joint inflammation
- Supports brain health
- Improves cardiovascular function
- Helps clear senescent cells
Most senolytic supplements[6] now include piperine to boost absorption. Taking turmeric with black pepper and healthy fats further improves uptake.
Senolytic Protocols and Practical Application

Most senolytic protocols use intermittent dosing rather than daily supplementation to maximize cellular health benefits while minimizing side effects. Supplement stacking combines multiple compounds with senolytic properties, though safety considerations make medical supervision essential for certain populations.
Intermittent Dosing Strategies
Senolytic supplements work best when taken periodically rather than daily. This approach allows the body to clear senescent cells without overwhelming natural processes.
The most studied protocol involves taking senolytics for two consecutive days every three to six months. This timing mimics successful clinical trials and reduces the risk of side effects.
Common Dosing Schedules:
- Monthly approach: Two consecutive days per month
- Quarterly approach: Two to three consecutive days every three months
- Bi-annual approach: Three consecutive days twice yearly
The Life Extension Senolytic Activator follows a monthly protocol. Users typically take the supplement for two days, then pause for four weeks.
Intermittent dosing prevents the body from developing tolerance. It also allows healthy cells to recover between treatment cycles.
Some researchers suggest adjusting frequency based on age. Younger individuals may benefit from less frequent dosing, while older adults might need more regular cycles.
Senolytic Supplement Stacking
Combining different senolytic compounds can target multiple pathways for removing damaged cells. The most effective combinations use both natural and synthetic approaches.
Popular Stacking Options:
- Quercetin + Dasatinib (requires prescription)
- Fisetin + Quercetin + Curcumin
- Quercetin and dasatinib combination[1] for maximum effectiveness
Quercetin works well with other flavonoids. It enhances absorption and bioavailability of compounds like fisetin.
Curcumin adds anti-inflammatory support to senolytic protocols. Black pepper extract helps improve curcumin absorption by up to 2000%.
Timing Considerations:
- Take fat-soluble compounds with meals
- Space different supplements 2-4 hours apart
- Use piperine to enhance absorption
Some products combine multiple senolytic activators in single formulations. These eliminate guesswork but may not allow for personalized dosing.
Safety Considerations and Who Should Avoid Use
Certain populations should avoid senolytic supplements without medical supervision. These compounds can interact with medications and existing health conditions.
High-Risk Groups:
- Pregnant or breastfeeding women
- People taking blood thinners
- Cancer patients undergoing treatment
- Individuals with bleeding disorders
Dasatinib poses significant risks[1] including reduced platelet count and bleeding complications. This pharmaceutical requires careful medical monitoring.
Natural compounds carry fewer risks but still need caution. Quercetin can interfere with certain antibiotics and chemotherapy drugs.
Common Side Effects:
- Digestive upset
- Headaches
- Fatigue during dosing days
- Temporary inflammation
People over 65 should start with lower doses. Age-related changes in liver and kidney function affect how the body processes these compounds.
Those with autoimmune conditions should consult healthcare providers first. Senolytics may interfere with immune system medications.
Clinical Evidence and Real-World Results

Evidence from human and animal trials[7] shows senolytics can reduce damaged cells by 35-62% in tissue samples. These drugs have improved physical function in patients with lung disease and diabetes while extending lifespan in laboratory animals.
Findings from Animal and Human Trials
Animal studies demonstrate that senolytics extend both healthspan and lifespan in mice. These drugs eliminate senescent cells that cause tissue damage and inflammation.
Laboratory animals treated with senolytics showed improved physical function. They also lived longer than untreated animals.
The first human trial tested dasatinib plus quercetin[7] in patients with lung scarring. Participants showed better walking ability and physical performance after treatment.
A second human study involved people with diabetes and kidney disease. The treatment reduced senescent cell markers by 35% in fat tissue and 38% in skin cells.
Blood tests showed lower inflammation markers 11 days after treatment. This suggests the drugs worked throughout the body, not just in specific tissues.
Effects on Age-Related Diseases
Senolytics target multiple age-related conditions by removing damaged cells that drive disease progression. Research shows promise for cardiovascular disease, frailty, and other chronic conditions.
In animal models, these drugs prevented age-related muscle loss and bone weakness. They also reduced heart problems and blood vessel damage.
Heart disease studies show senolytics can improve cardiac function. The drugs help remove senescent cells that cause heart tissue scarring and poor blood flow.
Frailty responds well to senolytic treatment in laboratory studies. Animals showed better strength, coordination, and energy levels after receiving these medications.
Some research suggests potential benefits for cancer prevention. Removing senescent cells may reduce inflammation that promotes tumor growth.
Benefits for Healthspan, Lifespan, and Physical Function
Physical improvements appear quickly after senolytic treatment. Patients in human trials showed better mobility and strength within days of starting medication.
Healthspan measures how long people stay healthy and active. Animal studies show senolytics can extend this period significantly.
Walking speed and endurance improved in human participants. Chair rise tests and balance scores also got better after treatment.
The drugs work intermittently rather than continuously. Patients take them for just a few days, then stop for weeks or months.
Lifespan extension has only been proven in animals so far. Mice lived longer when given senolytics compared to untreated animals.
Current trials focus on healthy aging rather than treating specific diseases. Researchers want to prevent multiple age-related problems at once.
Supporting Cellular Health Beyond Senolytics

While senolytics target senescent cells directly, several complementary approaches can enhance cellular health and longevity. Exercise, dietary modifications, and antioxidant combinations offer promising pathways to support healthy aging alongside emerging senolytic research.
Lifestyle Factors: Exercise and Caloric Restriction
Regular exercise activates multiple cellular pathways that combat aging at the molecular level. Physical activity stimulates autophagy, the process by which cells remove damaged components and recycle materials.
Exercise also reduces chronic inflammation, a key driver of cellular senescence. Studies show that consistent aerobic activity and resistance training help maintain mitochondrial function and cellular energy production.
Caloric restriction represents another powerful intervention for cellular health. Research demonstrates that reducing caloric intake by 20-30% while maintaining proper nutrition can extend lifespan in various organisms.
This approach works by:
- Activating SIRT1 proteins that protect against cellular damage
- Reducing oxidative stress throughout the body
- Improving insulin sensitivity and metabolic function
- Decreasing inflammation markers
The Mayo Clinic and other research institutions[2] are actively studying how exercise and nutrition can lower cellular senescence in controlled clinical trials.
Combining Antioxidants and Supplements
Antioxidants play a crucial role in protecting cells from oxidative damage that accelerates aging. Natural compounds like quercetin, resveratrol, and curcumin demonstrate senolytic-like properties while providing additional cellular benefits.
Foods rich in polyphenols[8] such as strawberries, dark chocolate, and green tea may help target senescent cells naturally. These compounds work synergistically with the body’s existing cellular repair mechanisms.
Key antioxidant combinations include:
- Quercetin + Dasatinib: A well-studied senolytic combination
- Fisetin: Found in strawberries and shown to clear senescent cells
- EGCG: Green tea compound with anti-aging properties
- NAD+ precursors: Support cellular energy production
However, experts caution that over-the-counter supplements aren’t regulated by the FDA[2] and may contain inconsistent doses or quality.
Emerging Trends and Future Research
Anti-aging medicine continues to evolve as research institutions like the Scripps Institute advance our understanding of cellular aging mechanisms. Current trends focus on personalized approaches that consider individual genetic and metabolic profiles.
Researchers are exploring combination therapies that integrate senolytics with cancer therapy approaches. This dual strategy targets both senescent cells and potentially malignant cells using similar cellular pathways.
Future research directions include:
- Developing more precise senolytic activators
- Creating life extension protocols combining multiple interventions
- Investigating optimal timing and dosing for senolytic treatments
- Understanding how different populations respond to various approaches
Clinical trials are examining whether combining lifestyle interventions with targeted supplements can achieve better outcomes than single approaches. These studies measure bone density, glucose metabolism, and organ function to assess comprehensive health improvements.
Frequently Asked Questions

Research shows that fisetin stands out as the most potent natural senolytic compound, while dasatinib combined with quercetin leads pharmaceutical options. These compounds carry specific risks and benefits that vary based on individual health factors.
Which senolytic drugs are currently considered most potent?
Fisetin ranks as the most potent senolytic[3] based on preclinical studies that tested 10 different compounds. It outperformed even quercetin in clearing senescent cells from both human and mouse tissue samples.
The combination of quercetin and dasatinib shows the most promise[1] in clinical applications. These two compounds work together to target senescent cells across multiple tissue types.
Dasatinib was originally developed as a cancer drug for leukemia treatment. When paired with the natural flavonoid quercetin, it creates a powerful senolytic combination that has advanced to human clinical trials.
Navitoclax represents another pharmaceutical option currently under investigation. This experimental cancer drug targets proteins that help senescent cells survive in the body.
What are the potential adverse effects associated with senolytic supplements?
Senolytic supplements often contain much lower doses than needed for effectiveness[2], according to medical experts. This creates a gap between marketed products and research-backed dosing.
Dasatinib carries significant risks including reduced platelet count and increased bleeding risk. Patients may also experience fatigue, nausea, and digestive problems when taking this pharmaceutical compound.
Navitoclax poses the most serious side effect risk through thrombocytopenia. This condition causes dangerously low platelet levels that require careful medical monitoring to prevent life-threatening bleeding.
Natural compounds like quercetin can cause headaches and stomach upset at higher doses. Fisetin’s long-term safety profile remains under study with limited human data available.
Medical professionals warn that some aging interventions could cause significant harm[2] without proper supervision. This makes consultation with healthcare providers essential before starting any senolytic regimen.
Can you list senolytic agents that are backed by substantial scientific research?
Quercetin has the most extensive research backing among natural senolytics. This flavonoid appears in apples, onions, and capers while demonstrating consistent senolytic activity in multiple studies.
Fisetin shows strong research support with studies demonstrating lifespan extension in animal models. This compound appears naturally in strawberries, apples, and persimmons with proven ability to clear senescent cells.
The dasatinib and quercetin combination has progressed to human clinical trials. Research shows this pairing improves physical function in patients with idiopathic pulmonary fibrosis.
Curcumin from turmeric displays senolytic properties in laboratory studies. While research continues, this compound shows promise for targeting senescent cells through multiple pathways.
Green tea catechins represent another research-supported option. These compounds found in tea leaves demonstrate potential senolytic activity alongside their established antioxidant benefits.
Which foods have been identified as having senolytic properties?
Apples and onions contain high levels of quercetin, making them accessible dietary sources. These versatile foods can be added to salads, cooked dishes, or consumed raw for senolytic benefits.
Strawberries and persimmons provide significant amounts of fisetin. These fruits can be eaten fresh, added to smoothies, or incorporated into various recipes for natural senolytic support.
Turmeric contains curcumin, which shows senolytic activity in research studies. This spice can be used in cooking or taken as a supplement to potentially target senescent cells.
Green tea provides catechins that may function as senolytics. Regular consumption of this beverage offers potential anti-aging benefits through multiple biological pathways.
Capers contain concentrated quercetin levels higher than most other food sources. These small flower buds can be added to Mediterranean dishes for both flavor and potential senolytic effects.
Are there any comprehensive reviews on the effectiveness of senolytic supplements?
Current research lacks comprehensive long-term data on senolytic supplement effectiveness in humans. Most studies focus on animal models or small-scale clinical trials with limited participant numbers.
Medical centers like Cedars-Sinai have published reviews highlighting the gap between supplement marketing and scientific evidence. These analyses show that commercial products often contain insufficient active compounds.
The scientific literature contains multiple preclinical studies but few large-scale human trials. This creates uncertainty about optimal dosing, safety profiles, and real-world effectiveness.
Research reviews consistently emphasize the need for more human clinical data. The field remains in early stages despite promising preliminary results in laboratory and animal studies.
Professional medical organizations recommend caution when evaluating senolytic supplement claims. The evidence base continues to develop but lacks the depth needed for definitive effectiveness conclusions.
What are the latest advancements in senolytic therapy research?
Clinical trials are expanding to test senolytic combinations in various age-related diseases. Researchers are investigating applications for cardiovascular disease, cognitive decline, and metabolic disorders.
New synthetic senolytics are entering early-stage development with improved selectivity. These compounds aim to target senescent cells more precisely while reducing side effects on healthy tissue.
Biomarker research is advancing to help identify individuals who might benefit most from senolytic therapy. Scientists are developing tests to measure senescent cell burden and treatment response.
Dosing studies are investigating intermittent treatment schedules rather than daily supplementation. This approach may maximize benefits while minimizing potential adverse effects from continuous exposure.
Combination therapies are being explored that pair senolytics with other anti-aging interventions. Research includes combinations with exercise, caloric restriction, and other longevity-focused treatments.
References
- Senolytics: Benefits, side effects, function, supplements, food. https://longevity.technology/clinics/what-are-senolytics-benefits-side-effects-and-research/ Accessed October 21, 2025
- 403 Forbidden. https://www.cedars-sinai.org/blog/are-senolytic-supplements-right-for-me.html Accessed October 21, 2025
- What Are Senolytics? The Science and Benefits. https://www.qualialife.com/senolytics-science-and-benefits Accessed October 21, 2025
- Top 6 Natural Approaches to Aging: Defining Senolytic Supplements + More. https://www.iherb.com/blog/top-natural-approaches-to-aging-senolytic-supplements/1809 Accessed October 21, 2025
- Anti-Aging Benefits of Senolytics. https://www.lifeextension.com/magazine/2021/6/senolytics-anti-aging-advance Accessed October 21, 2025
- Are The Natural Senolytic Compounds in Food Enough to Experience Senolytic Benefits?. https://www.qualialife.com/senolytics-in-food Accessed October 21, 2025
- Just a moment.... https://www.thelancet.com/journals/ebiom/article/PIIS2352-3964(19)30641-3/fulltext Accessed October 21, 2025
- 10 Longevity Foods That Kill Zombie Cells. https://honehealth.com/edge/foods-that-kill-zombie-cells/ Accessed October 21, 2025
